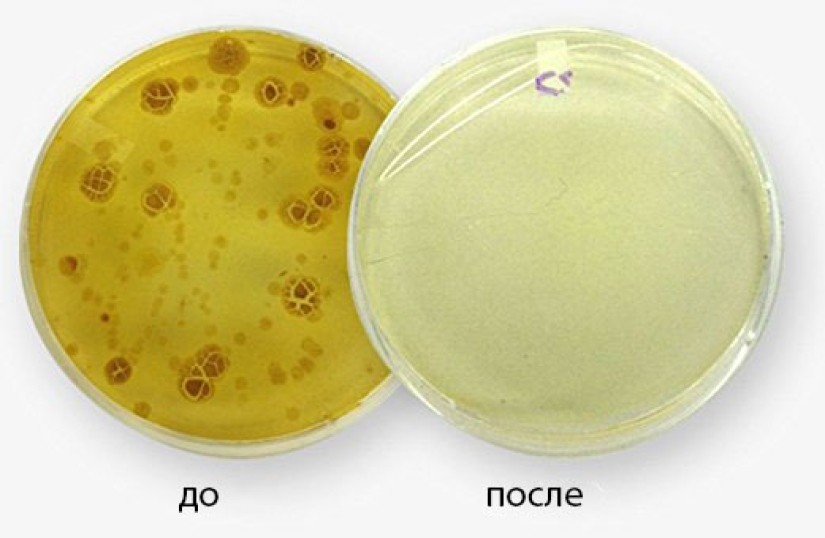
"Los teléfonos inteligentes son 18 veces más sucios que los inodoros": los científicos han aprendido a matar los gérmenes en nuestros dispositivos

"Los teléfonos inteligentes son 18 veces más sucios que los inodoros": los científicos han aprendido a matar los gérmenes en nuestros dispositivos
Categorias: Tecnología
Por Pictolic https://mail.pictolic.com/es/article/los-telefonos-inteligentes-son-18-veces-ms-sucios-que-los-inodoros-los-cientficos-han-aprendido-a-matar-los-germenes-en-nuestros-dispositivos.htmlAlguna vez te has preguntado dónde se acumula tanta suciedad, polvo y todo tipo de suciedad en el teléfono, una vez que le quitas la funda? Extremadamente desagradable, estamos de acuerdo. Y aún más desagradable es el hecho de que en nuestros teléfonos inteligentes, que llevamos a todas partes, incluso a la cama, hay 18 veces más bacterias que en el inodoro de un baño público.
Por supuesto, puede convertirse en un maníaco del lavado de manos o mantener su teléfono en una bolsa de celofán, cambiándolo cada cinco minutos, pero es poco probable que esto limpie su teléfono inteligente.


PhoneSoap ha aparecido en el mercado, lo que resolverá el problema de los gérmenes y la aprensión.

El nombre del producto es revelador — "jabón para el teléfono". Esto no significa que tendrá que sumergir su teléfono en un baño con agua jabonosa. PhoneSoap es una funda para teléfono con rayos ultravioleta desinfectantes incorporados.

Los rayos ultravioleta matan los gérmenes, que el calor de un teléfono inteligente que funciona solo ayuda a multiplicar, y el estuche también carga su dispositivo.
Palabras clave: Suciedad | Gérmenes | Teléfonos inteligentes | Ultravioleta | Limpieza
Publicar artículo de noticiasArtículos Recientes
En el otoño de 1972, Bill Yates viajó por el campo en las cercanías de Tampa, Florida. En ese momento, estudiaba fotografía en ...
El clima frío severo no abandona sus posiciones. Le ofrecemos admirar las fotos mágicas de la Europa de invierno, porque la nieve ...
Artículos relacionados
Cuando se esperan invitados en la casa, tratan de poner todo en orden que es posible. Nadie quiere mostrar el lado equivocado de su ...
Creemos que algún día aparecerán monumentos a los trabajadores de reparación de computadoras en las plazas de nuestras ...
El inodoro es habitualmente percibido por todos como algo muy sucio. Y esto es absolutamente cierto. Incluso un inodoro de aspecto ...

Vladimir Lyubarov es un artista rural que pinta imágenes de la vida real. Pero da vida a personajes, aves y animales asombrosos, y ...